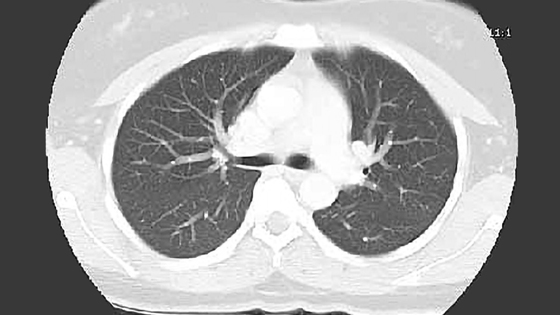

Учёные из Кейсовского университета Западного резервного района разработали алгоритмы искусственного интеллекта, способные определять, будет ли эффективна иммунотерапия для больных раком лёгкого.
Исследователи научили программу находить ранее незаметные изменения в изображениях с компьютерной томографии (КТ). Она сравнивает первые такие изображения, полученные при диагностике рака, и те, что сделали после первых двух-трёх циклов иммунотерапии.
На сегодняшний день данный метод лечения помогает примерно 20% раковых больных. От химиотерапии он отличается тем, что вводимые лекарства помогают иммунной системе человека самостоятельно бороться с раковыми клетками, а не убивать их (и всё, что попадётся в поле зрения). Поэтому иммунотерапия более щадящий способ лечения, но и довольно дорогой. Порой пациенты платят огромные деньги за терапию, которая им не помогает. Новый инструмент позволит избежать этой ситуации.